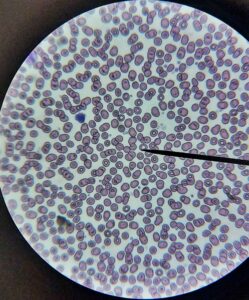

Besucher:innen, die an unserem Gymnasium interessiert sind
Offene Klassenzimmertüren
Reinschnuppern ins vielfältige Angebot
Genuss für Augen und Ohren
So lässt sich unser Open Day 2023 kurz und knapp zusammenfassen. Zahlreiche interessierte Jugendliche haben mit ihren Eltern die Möglichkeit genutzt, unser Gymnasium hautnah zu erleben. Dabei wurden sie von unseren Schüler:innen durch die bunt-gemischten Aktivitäten unserer Zweige geführt: Vom Programmieren und Modellieren im Medien und Kunst-Bereich über das Sezieren und Mikroskopieren im naturwissenschaftlichen MeNaTec-Zweig bis hin zum Musizieren und Komponieren unserer Musiker:innen – von allen unseren Zweigen konnten sich die Besucher:innen ein Bild machen. Mit der VR-Brille virtuelle Welten erkunden, die perfekte Akustik im neuen Band-Raum erleben oder in die Welt der lateinischen, französischen oder spanischen Sprache eintauchen – die verschiedensten Stationen repräsentierten das vielfältige Angebot einer fundierten, zukunftsorientierten Bildung, die unser Gymnasium bietet.
Neugierig geworden? Interessierte sind weiterhin herzlich zu einem Schnuppervormittag eingeladen! Und Informationen rund um die Anmeldung/Aufnahme gibt’s hier.